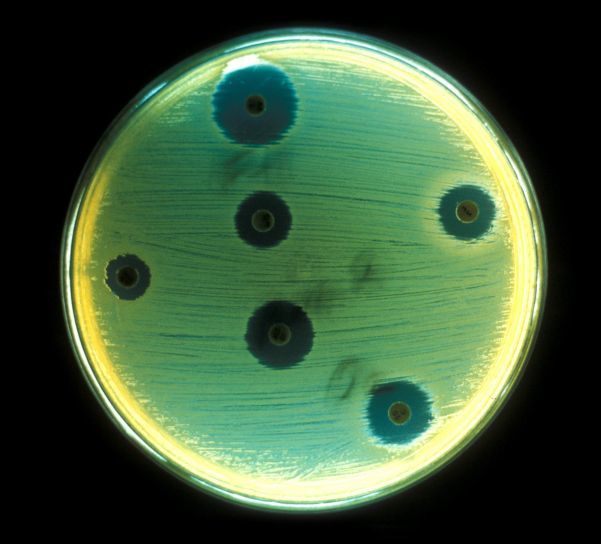

Laboration Bakterier 03B
Grundskola
·
Årskurs 9
·
Biologi
·
Trönningeskolan, Halmstad
·
9 december 2018
Kroppens immunförsvar hjälper oss att bekämpa sjukdomar vi fått från till exempel bakterier och virus. Vi kommer under detta avsnittet att lära oss mer om hur det fungerar och hur vi kan skydda oss från till exempel bakterier som kan göra oss sjuka.
Matriser i planeringen
Laboration Bakterier
Uppgifter
Innehåller inga uppgifter